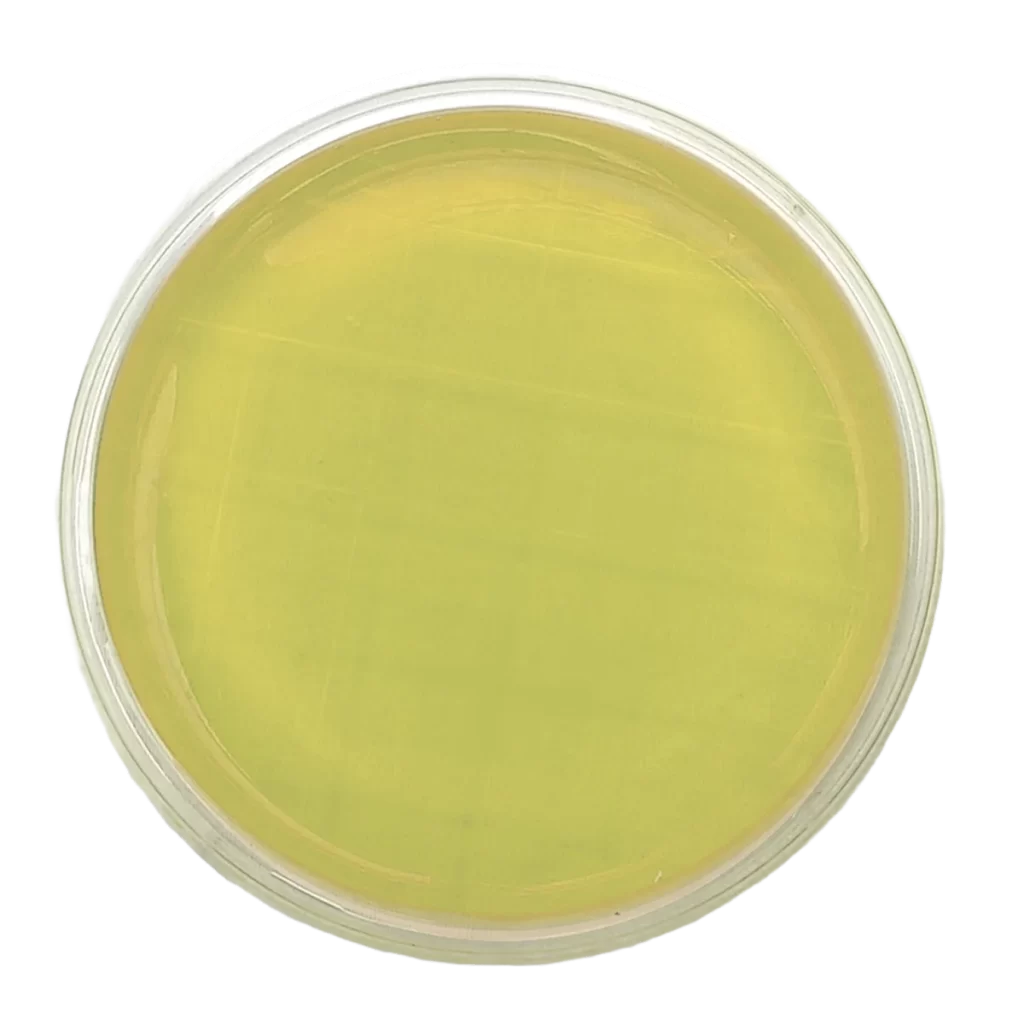
AGAR PLATE COUNT (PCA) - Irradiado - Placa tipo Rodac Ø 65 mm x 15 mm.
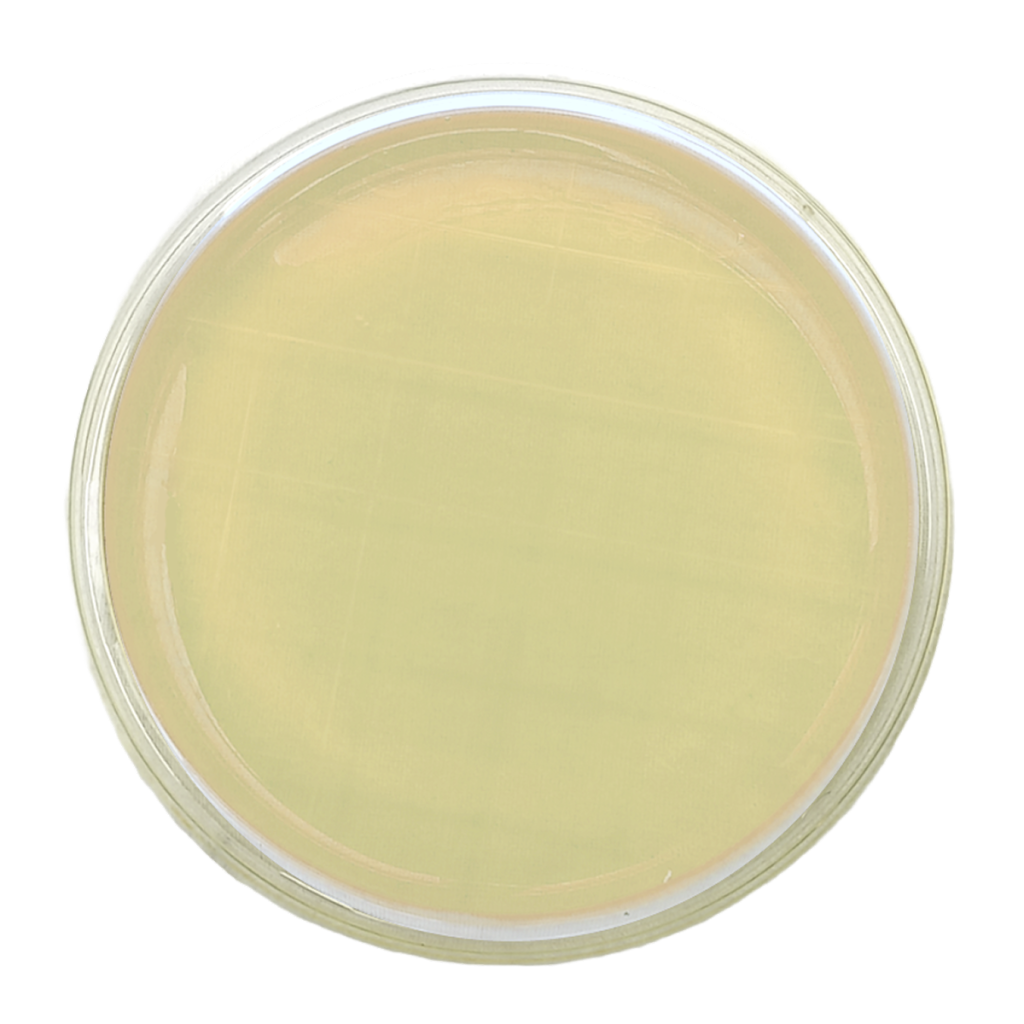
Agar R2A – Irradiado - Placa tipo Rodac Ø 65 mm x 15 mm.

EXPLORA TODO EN MICROBIOLOGÍA
ESPECIALISTAS EN MONITOREO AMBIENTAL
MONITOREO
AMBIENTAL
¿BUSCA ASESORAMIENTO U ORIENTACIÓN SOBRE MONITOREO AMBIENTAL?
MEDIOS
LISTOS PARA USAR
¿NECESITA AYUDA PARA DECIDIR QUÉ MEDIOS LISTOS DEBE USAR?
PARA USAR
Nuestro enfoque
es siempre el cliente
SOLUCIONES A MEDIDA
ENTREGA GARANTIZADA
ASESORAMIENTO TÉCNICO
Brindamos Soporte técnico referente a programas de Monitoreos Ambientales, Validaciones de Metodologias Analiticas y Validaciones de Procesos Asepticos (Media Fill) para alcanzar los estándares nacionales e internacionales.
SERVICIO DE ANÁLISIS
Como laboratorio externo de control de calidad, nos caracterizamos por lograr empatía con nuestros clientes, dado que entendemos su necesidad de tercerizar sus análisis alcanzando los más altos estándares de rigurosidad, profesionalismo y en tiempos que establezcan.
Nuestro enfoque
es siempre el cliente
SOLUCIONES A MEDIDA
ENTREGA GARANTIZADA
ASESORAMIENTO TÉCNICO
Brindamos Soporte técnico referente a programas de Monitoreos Ambientales, Validaciones de Metodologias Analiticas y Validaciones de Procesos Asepticos (Media Fill) para alcanzar los estándares nacionales e internacionales.
SERVICIO DE ANÁLISIS
Como laboratorio externo de control de calidad, nos caracterizamos por lograr empatía con nuestros clientes, dado que entendemos su necesidad de tercerizar sus análisis alcanzando los más altos estándares de rigurosidad, profesionalismo y en tiempos que establezcan.
Download ebook
Please complete the form and select the ebook to download from the list
Descargar ebook
Por favor complete el formulario y seleccione en la lista el ebook a descargar
CONTÁCTENOS
Argentina:
Buenos Aires. Argentina
Sargento Cabral 2431
Vicente López
CP 1605
Tel: +54 9 11 3027-3162
LATAM
Asunción, Paraguay
Misiones 593 e/ Perú
CP 1102
Tel : +57 310 4594786
EEUU:
Florida. EEUU
1101 Brickell Avenue South, Tower 8th Floor, Miami,
FL 33131
Tel: (305) 381- 1855
Asesoramiento y ventas:
ventas@mikrobiol.com